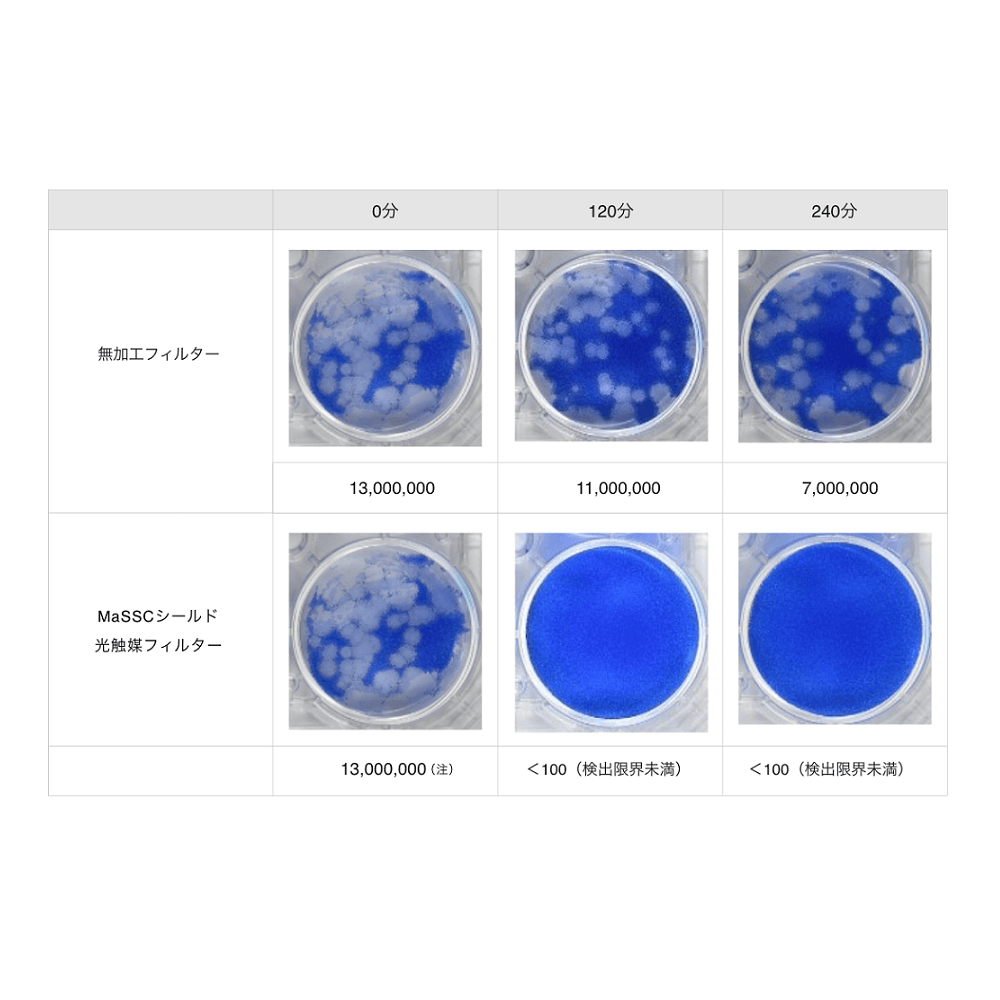

商品情報
- JANコード
- 4562352860054
あなたへのおすすめ
カテゴリから探す
-
サンドラッグ(61889)
-
医薬品・医薬部外品(2132)
- ドリンク剤(139)
- ビタミン・滋養強壮・保健薬(173)
- 鎮痛解熱剤(65)
- 風邪薬・のど・うがい薬(291)
- 口腔用剤(29)
- 鼻炎薬(81)
- 胃腸薬(115)
- 整腸薬・下痢止め(55)
- 便秘薬・浣腸(85)
- 痔治療薬(24)
- 外用鎮痛消炎薬(187)
- 漢方薬・生薬(240)
- 不眠・不安・イライラ(7)
- 眠気覚まし(4)
- 乗り物酔い止め(26)
- 局方品・検査薬・忌避殺虫・その他(87)
- 傷薬・あかぎれ・傷跡(34)
- 湿疹薬(13)
- にきび(17)
- 乾燥肌(30)
- 湿疹薬(114)
- 消毒薬(18)
- 水虫薬(39)
- 虫刺され(28)
- 皮膚病用石鹸(4)
- 頭皮・毛髪の薬(52)
- 目薬・洗眼薬(175)
- 衛生用品(2337)
- 健康食品(1478)
-
飲料・食品(2560)
- シリアル・オートミール(48)
- お茶・コーヒー・ココア(112)
- お茶・コーヒー・紅茶(77)
- 果汁・乳酸飲料(60)
- スポーツドリンク(45)
- 炭酸飲料(38)
- ミネラルウォーター(15)
- 炭酸水(8)
- 栄養補助(237)
- お菓子・スイーツ(482)
- 珍味(144)
- 飴・ガム・グミ(122)
- お酢ドリンク(2)
- 野菜ジュース(12)
- 特定保健用食品(飲料)(31)
- 機能性表示食品(飲料)(34)
- 栄養機能食品(飲料)(3)
- 乾物(15)
- のり・お茶漬け・ふりかけ(35)
- 小麦粉・片栗粉類(6)
- そば・うどん(37)
- パスタ類(37)
- カップ麺・袋麺(75)
- 味噌・即席味噌汁(24)
- 調味料(48)
- 食用油(12)
- 缶詰・瓶詰(44)
- インスタントレトルト(110)
- 冷凍食品(192)
- 米類(34)
- ス-プ類(26)
- デザート(19)
- ジャム・はちみつ(15)
- 市乳・洋日配(320)
- その他酒類(13)
- 日用品・洗剤(9828)
- 介護用品(928)
- ベビー用品(1263)
- 衣料品(346)
-
化粧品(5650)
- 基礎化粧品(洗顔・クレンジング)(628)
- 基礎化粧品(化粧水)(381)
- 基礎化粧品(乳液)(111)
- 基礎化粧品(クリーム・ジェル)(225)
- 基礎化粧品(美容液・オイル)(200)
- 基礎化粧品(パック)(260)
- ボディケア(医薬品)(2)
- ボディケア(242)
- ハンドケア(医薬品)(12)
- ハンドケア(87)
- フットケア(65)
- リップケア(医薬品)(2)
- リップケア(114)
- 日焼け止め・サンオイル(123)
- デオドラント・制汗(199)
- ムダ毛ケア(103)
- フレグランス・香水(53)
- ベースメイク・化粧下地(371)
- メイクアップ(897)
- ネイル(421)
- 化粧小物(370)
- トラベル(13)
- 美容機器・雑貨(42)
- 男性化粧品(729)
-
化粧品(ブランド別)(2483)
- エリクシール(資生堂)(32)
- マキアージュ(資生堂)(141)
- エリクシールシュペリエル(資生堂)(20)
- HAKU(資生堂)(14)
- リバイタル(資生堂)(20)
- プリオール(資生堂)(34)
- &フェイス(資生堂)(1)
- dプログラム(資生堂)(64)
- アベンヌ(資生堂)(41)
- インテグレート(資生堂)(26)
- インテグレートグレイシィ(資生堂)(18)
- マジョリカマジョルカ(資生堂)(19)
- アクアレーベル(資生堂)(38)
- その他資生堂(14)
- Suisai(スイサイ)(カネボウ)(7)
- DEW(カネボウ)(22)
- ケイト(カネボウ)(168)
- アリィー(カネボウ)(6)
- メディア(カネボウ)(76)
- エビータ(カネボウ)(13)
- その他カネボウ(3)
- エスプリーク(コーセー)(110)
- Visee(コーセー)(171)
- エスプリークエクラ(コーセー)(6)
- ONE BY KOSE(コーセー)(23)
- カルテ クリニティ(コーセー)(7)
- ルシェリ(コーセー)(5)
- スティーブンノル(コーセー)(81)
- 雪肌精(コーセー)(42)
- その他コーセー(28)
- ソフィーナグレイス(ソフィーナ)(3)
- ファインフィット(ソフィーナ)(16)
- ソフィーナボーテ(ソフィーナ)(8)
- プリマヴィスタ(ソフィーナ)(34)
- プリマヴィスタディア(ソフィーナ)(11)
- 乾燥肌のための美容液洗顔シリーズ(ソフィーナ)(1)
- ソフィーナiP(ソフィーナ)(18)
- その他ソフィーナ(2)
- ファシオ(コーセー)(247)
- ネイチャー&コー(コーセー)(6)
- カルテヒルドイド(コーセー)(22)
- エテュセ(その他ブランド)(20)
- キャンメイク(その他ブランド)(168)
- セザンヌ(その他ブランド)(173)
- メイベリン(その他ブランド)(91)
- リンメル(その他ブランド)(32)
- レブロン(その他ブランド)(48)
- スウィーツスウィーツ(その他ブランド)(1)
- パルガントン(その他ブランド)(6)
- フェルム(その他ブランド)(38)
- ちふれ(その他ブランド)(278)
- Kiss(その他ブランド)(10)
- 家電・インテリア・生活雑貨(6609)
- ホーム・キッチン(4013)
- 文具(4808)
- 園芸用品(1722)
- ペット(5286)
- スポーツ・レジャー(181)
-
DIY・工具(3859)
-
医薬品・医薬部外品(2132)
ショップ内検索

![[マーナxJALショッピング]Shupattoコンパクトバッグ Drop JAL客室乗務員(LC)スカーフ柄](https://ec.jal.co.jp/img/0002/goods/L/2690H_2690H.jpg)
![[JALオリジナル]肩掛けトート レッド](https://ec.jal.co.jp/img/0002/goods/L/4717J_4717J03.jpg)
![[ハリウッド ランチ マーケット]ストレッチフライス クルーネック別注半袖Tシャツ](https://ec.jal.co.jp/img/0002/goods/L/3470J_3470J01.jpg)


臭い、花粉、ウイルス対策、これ1台! ●リビングや会議室など広い空間の空気を、パワフルに消臭・除菌します。●一台で約28畳分の部屋を消臭除菌いたします。だから密室になりがちな会議室などもカバーすることが可能です。●お客様が安心してご利用できるための1つの提案です。空間を消臭除菌し、安心安全でリラックスできる空間を提供いたします。●一般的な空気清浄機のフィルターは、菌やウイルス、臭いとなるガス成分を「吸着」させる方式ですが、ブルーデオM型は光除菌フィルターで「元から分解して除去」します。●オゾン、イオン、次亜塩素酸などの放出はゼロ。有害因子を本体内部の光除菌フィルター上で分解・除去してキレイな空気でお部屋を満たします。●コンセントを差して、電源ボタンを押すだけ。 ひとつのボタンで、電源ON/OFF、及び風量切り替えができます。●HEPAフィルターを搭載で集塵力が大幅にアップ。推奨床面積は約28畳に対応し、大空間を消臭・除菌します。 【仕様】 ●サイズ:幅300×奥行320×高さ700mm●重量:約7.6kg●電源:100V●推奨床面積:約28畳
サイズ
サイズ:幅300×奥行320×高さ700mm
カラー
ホワイト
問い合わせ先
マスクフジコー 問合せ:0120-80-2450 受付時間:9~17時 (平日のみ)
メーカー名(製造販売会社)
マスクフジコー
ブランド名
ブルーデオ
原産国
日本
広告文責
株式会社サンドラッグ/電話番号:0120-009-368
JAN
4562352860054
※パッケージ・デザイン・内容等は、リニューアルにより予告なしに変更される場合がありますので、予めご了承ください。
※お届け地域によっては、表記されている日数よりもお届けにお時間を頂く場合がございます。
空気 清浄機 除菌 光 消臭 リビング 会議室 美容室 店 ペット 花粉